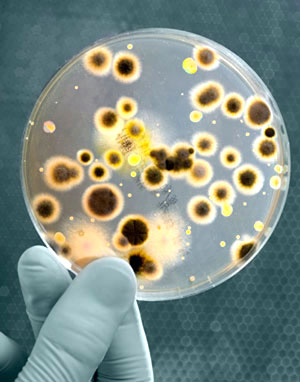

Theo thông tin ghi nhận, hiện nay thành phố New York ở Mỹ đã bùng phát bệnh Legionnaires là một bệnh viêm phổi nghiêm trọng ảnh hưởng đến sức khỏe và tính mạng bệnh nhân. Ở nước ta, mặc dù bệnh này xuất hiện lẻ tẻ ở một số nơi nhưng cũng rất cầnquan tâm tìm hiểu để có biện pháp chủ động phòng ngừa.
Từ ngày 10/7/2015 đến nay, tại đây đã có 65 người mắc bệnh với 4 trường hợp bị tử vong và còn có khả năng tăng thêm, thống kê mỗi năm ở Mỹ có khoảng 8.000 đến 18.000 người phải nhập viện để điều trị do căn bệnh này.
|
| Vi khuẩn Regionella gây bệnh Regionnaires (ảnh minh họa) |
Đặc điểm bệnh Legionnaires
Bệnh Legionnaires gây nên do nhiễm vi khuẩn Legionella có trong nguồn nước sử dụng và được cộng đồng người dân ngày càng quan tâm vì số tử vong với bệnh này đang gia tăng đáng kể. Đây là một bệnh nguy hiểm gây viêm phổi nặng và có khả năng đe dọa đến tính mạng người bệnh. Đối với người cao tuổi, sức đề kháng kém sẽ có nguy cơ nhiễm vi khuẩn cao; những người hay hút thuốc lá, uống rượu bia, tiểu đường cũng là đối tượng dễ bị nhiễm bệnh. Trong điều kiện tự nhiên, vi khuẩn Legionella phát triển mạnh ở nhiệt độ 30-37oC, bị ngưng trệ hoạt động ở 40-45oC và chết ở nhiệt độ trên 70oC. Đặc điểm của loại vi khuẩn này là sinh sống và phát triển trong các loài vi sinh vật khác như một dạng amíp. Màng sinh học cũng sẽ xuất hiện ở tất cả những ống dẫn nước, bồn chứa nước, nơi có điều kiện sinh sống và phát triển tối ưu cho vi khuẩn gây bệnh với điều kiện nhiệt độ thích hợp. Vi khuẩn Legionella hiện diện khá phổ biến ở các hồ nước tự nhiên, bùn và đất ẩm nhưng ít khi gây nguy hại cho con người. Tuy vậy con người có thể bị mắc bệnh khi hít hoặc nuốt phải những giọt nước nhỏ có chứa vi khuẩn Legionella. Trên cơ sở này, có thể xác định những nơi nguy hiểm có khả năng mang mầm bệnh vi khuẩn là vòi tắm trong khách sạn, bệnh viện, nhà dưỡng lão, hồ bơi, các trung tâm thể thao; phòng tắm ở những spa và nhà nghỉ, máy thông khí hay điều hòa không khí với màng lọc ẩm, tháp hạ nhiệt, những khu vực có vòi nước phun để làm mát hoặc tăng độ ẩm...
Triệu chứng bệnh lý
Vi khuẩn Legionella khi xâm nhập vào cơ thể con người có khả năng gây bệnh dưới hai dạng là thể không viêm phổi và thể viêm phổi.
Thể không viêm phổi có bệnh lý giống bệnh cúm cấp tính, xảy ra có giới hạn và thường kéo dài từ 2 đến 5 ngày. Thời gian ủ bệnh khoảng từ vài giờ đến 48 giờ. Triệu chứng lâm sàng chủ yếu được ghi nhận là sốt, ớn lạnh, nhức đầu, mệt mỏi và đau cơ... Thực tế hiếm có trường hợp tử vong có liên quan đến bệnh lý nhiễm vi khuẩn dưới thể dạng này.
Thể viêm phổi còn được gọi là bệnh Legionnaires, có thời gian ủ bệnh từ 2 đến 10 ngày nhưng có thể kéo dài lên đến 16 ngày vì các nhà khoa học đã ghi nhận ở một số trường hợp bệnh nhân tại những vụ dịch xảy ra trong thời gian gần đây. Khởi đầu người bệnh cũng có các triệu chứng như sốt, chán ăn, đau đầu, mệt mỏi và thờ ơ. Một số bệnh nhân có thể bị đau cơ, tiêu chảy và rối loạn tiêu hóa. Đồng thời có dấu hiệu ho nhẹ, khoảng một nửa bệnh nhân có đờm xuất hiện trong đường hô hấp; chừng 1/3 người bệnh có thể có chất đờm lẫn máu hoặc ho ra máu. Mức độ nghiêm trọng của bệnh xảy ra trong thời gian từ triệu chứng ho nhẹ đến viêm phổi nặng gây tử vong diễn biến rất nhanh. Các trường hợp tử vong có nguyên nhân chủ yếu do viêm phổi tiến triển nặng đưa đến trình trạng suy hô hấp, sốc và suy đa phủ tạng. Nếu bệnh không được phát hiện sớm, điều trị kịp thời sẽ có khả năng tiến triển trầm trọng hơn trong tuần đầu tiên với các yếu tố nguy cơ dẫn đến viêm phổi nặng, gây biến chứng suy hô hấp, sốc, suy thận cấp và suy đa phủ tạng. Việc điều trị bắt buộc phải sử dụng kháng sinh phù hợp, nếu có đáp ứng tốt, bệnh sẽ khỏi hoàn toàn sau vài tuần hoặc thậm chí vài tháng. Trong một số trường hợp, tình trạng viêm phổi có thể tiến triển nặng hoặc điều trị không đáp ứng hiệu quả sẽ có nguy cơ bị di chứng về não. Theo các nhà khoa học, tỷ lệ tử vong phụ thuộc vào mức độ nghiêm trọng của bệnh, sự đáp ứng điều trị của kháng sinh sử dụng, vị trí mắc bệnh và cơ địa của người bệnh vì bệnh thường xảy ra trầm trọng ở những bệnh nhân bị suy giảm miễn dịch. Tử vong do bệnh có thể chiếm tỷ lệ cao từ 40-80% ở những bệnh nhân suy giảm miễn dịch không được điều trị; tỷ lệ có khả năng giảm xuống còn 5-30% nếu được phát hiện, chẩn đoán, xử trí điều trị phù hợp và lẽ đương nhiên cũng còn phụ thuộc vào mức độ nghiêm trọng của biểu hiện triệu chứng lâm sàng. Thường tỷ lệ tử vong chung chiếm khoảng 5 đến 10% và được xem là loại bệnh hay mắc phải của cộng đồng khi có điều kiện tiếp xúc với những nơi có nguy cơ nhiễm vi khuẩn ở trong môi trường du lịch hoặc bệnh viện...
 |
| Bệnh Legionnaires gây bệnh lý viêm phổi nặng (ảnh minh họa) |
Cách phòng bệnh hiệu quả
Để phòng bệnh Legionnaires do nhiễm vi khuẩn Legionella gây nên, cần thực hiện những biện pháp đơn giản, ít tốn kém nhưng có thể mang lại hiệu quả cao như: Thiết kế ống dẫn nước và sử dụng các phụ kiện phù hợp như: chọn những vật liệu thích ứng, chọn đúng thủy lực cần thiết như lắp đặt không quá cao, không có góc chết; chú ý những nơi nguy hiểm có khả năng mang mầm bệnh vi khuẩn đã nêu trên, không kết nối ống nước song song với nồi hơi, không có thu hồi nhiệt thông qua gia nhiệt sơ bộ. Đồng thời nên duy tu bảo dưỡng và điều khiển hệ thống hoạt động thường xuyên, kiểm tra và vệ sinh nồi hơi định kỳ, kiểm tra xét nghiệm mức độ gây hại của của vi khuẩn. Ngoài ra cần xử lý hệ thống dẫn nước với chlorine dioxide, chất khử khuẩn mạnh không phụ thuộc vào độ pH; có thể phá hủy màng sinh học trong hệ thống ống nước để bảo vệ, ngăn ngừa hiện tượng tái nhiễm khuẩn với ưu điểm có hiệu quả kéo dài và ít ăn mòn hơn chlorine. Cũng có thể xử lý với ozone là chất khử khuẩn mạnh, đáng tin cậy trong việc loại bỏ màng sinh học, không có tồn dư nhưng có nhược điểm là không có tác dụng hiệu quả kéo dài trong việc xử lý nước và thường được ứng dụng tốt trong tháp hạ nhiệt, màng lọc khí. Ngoài những phương pháp mang lại hiệu quả, ít tốn kém về kinh tế đã nêu ở trên; các nhà khoa học cũng khuyến cáo có thể áp dụng một số biện pháp khác để phòng ngừa nhiễm vi khuẩn Legionella nhưng có mặt hạn chế như: Dùng nhiệt độ cao trên 70oC nhưng sẽ tốn nhiều năng lượng, có nguy cơ bị hỏng các ống nước và vòi nước, không khả thi đối với các đường ống dẫn nước dài; ở nhiệt độ nồi hơi trên 55oC chỉ hạn chế sự sinh trưởng của vi khuẩn trong nồi hơi chứ không phải trong toàn bộ hệ thống. Việc chiếu xạ UV cũng được thực hiện nhưng chỉ cần thiết trong trường hợp nhiễm amíp, không có hiệu quả kéo dài, không bảo vệ khỏi sự tái nhiễm màng sinh học. Trường hợp chiếu xạ UV phối hợp với siêu âm sẽ làm vi khuẩn được giải phóng khi xử lý amíp và màng sinh học nhưng không có hiệu quả kéo dài, không bảo vệ khỏi sự tái nhiễm màng sinh học, có chi phí cao, chiếm diện tích lớn. Kỹ thuật siêu lọc cũng không có hiệu quả kéo dài, không phá vỡ được màng sinh học. Sử dụng việc khử khuẩn bằng chlor là chất tẩy, điện phân thì không có hiệu quả khử khuẩn đầy đủ nếu không đồng thời điều chỉnh độ pH, không phá hủy được màng sinh học, có mùi khí chlor khó chịu do quá trình oxy hóa chất chloramine.
Điều cần quan tâm
Bệnh nhân bị nhiễm vi khuẩn Legionella thể không viêm phổi thường không đòi hỏi việc điều trị bằng kháng sinh mà chỉ cần xử trí bằng các biện pháp can thiệp triệu chứng là đủ. Đối với bệnh Legionnaires là thể bệnh viêm phổi do nhiễm vi khuẩn Legionella gây nên hiện nay chưa có vắc-xin phòng bệnh nên việc điều trị đòi hỏi bắt buộc phải sử dụng kháng sinh phù hợp sau khi được xét nghiệm chẩn đoán xác định. Bệnh có thể có nguy cơ đe dọa đến sức khỏe kể cả tính mạng của cộng đồng người dân khi bị viêm phổi nặng, vì vậy cần có những giải pháp cụ thể để thực hiện cách phòng bệnh hiệu quả như đã nêu ở trên. Mặc dù hiện nay bệnh Legionnaires xuất hiện lẻ tẻ ở một số nơi tại nước ta nhưng việc chủ động có biện pháp phòng ngừa vẫn là một vấn đề cần được quan tâm.